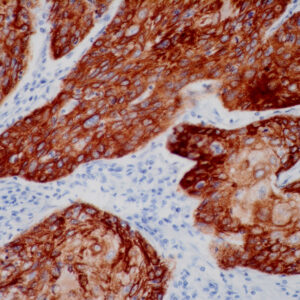
Anti-Cytokeratin 5
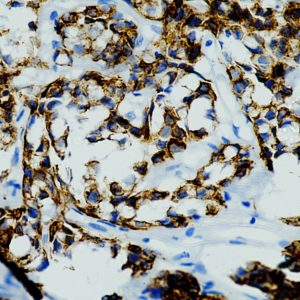
AN845

Both
Showing 301–320 of 703 resultsSorted by latest
-

Anti-GCDFP-15
Price range: $250.00 through $1,355.00 Select options This product has multiple variants. The options may be chosen on the product page -

Anti-Cytokeratin 15
Price range: $250.00 through $1,199.00 Select options This product has multiple variants. The options may be chosen on the product page -

Anti-Cyclin E1
Price range: $250.00 through $1,265.00 Select options This product has multiple variants. The options may be chosen on the product page -
Anti-Cytokeratin 5
Price range: $250.00 through $1,405.00 Select options This product has multiple variants. The options may be chosen on the product page -

Anti-ZAP-70
Price range: $250.00 through $1,320.00 Select options This product has multiple variants. The options may be chosen on the product page -

Anti-CD11b/ITAM
Price range: $250.00 through $960.00 Select options This product has multiple variants. The options may be chosen on the product page -

Anti-CD99
Price range: $250.00 through $1,149.00 Select options This product has multiple variants. The options may be chosen on the product page -

Anti-Cytokeratin 20
Price range: $250.00 through $1,439.00 Select options This product has multiple variants. The options may be chosen on the product page -

Anti-Cytokeratin 5
Price range: $250.00 through $1,175.00 Select options This product has multiple variants. The options may be chosen on the product page -

Anti-CD3 (T Cell)
Price range: $250.00 through $1,349.00 Select options This product has multiple variants. The options may be chosen on the product page -
Anti-Cytokeratin 6
Price range: $250.00 through $1,675.00 Select options This product has multiple variants. The options may be chosen on the product page -

Anti-PMS2
Price range: $250.00 through $848.00 Select options This product has multiple variants. The options may be chosen on the product page -

Anti-PU.1
Price range: $250.00 through $1,429.00 Select options This product has multiple variants. The options may be chosen on the product page -

Anti-CD138
Price range: $250.00 through $1,439.00 Select options This product has multiple variants. The options may be chosen on the product page -
![Anti-Human MCM2 [EP40]](https://biogenex.seosmo.click/wp-content/uploads/2021/10/AN834GP-1-300x300.jpg)
Anti-Human MCM2 [EP40]
Price range: $269.00 through $1,475.00 Select options This product has multiple variants. The options may be chosen on the product page -

Anti-SOX2
Price range: $250.00 through $995.00 Select options This product has multiple variants. The options may be chosen on the product page -

Anti-CD13
Price range: $250.00 through $1,049.00 Select options This product has multiple variants. The options may be chosen on the product page -

Anti-Cytokeratin 14
Price range: $250.00 through $1,009.00 Select options This product has multiple variants. The options may be chosen on the product page -

Anti-Oct-2
Price range: $250.00 through $995.00 Select options This product has multiple variants. The options may be chosen on the product page -

Anti-Survivin
Price range: $250.00 through $1,049.00 Select options This product has multiple variants. The options may be chosen on the product page

